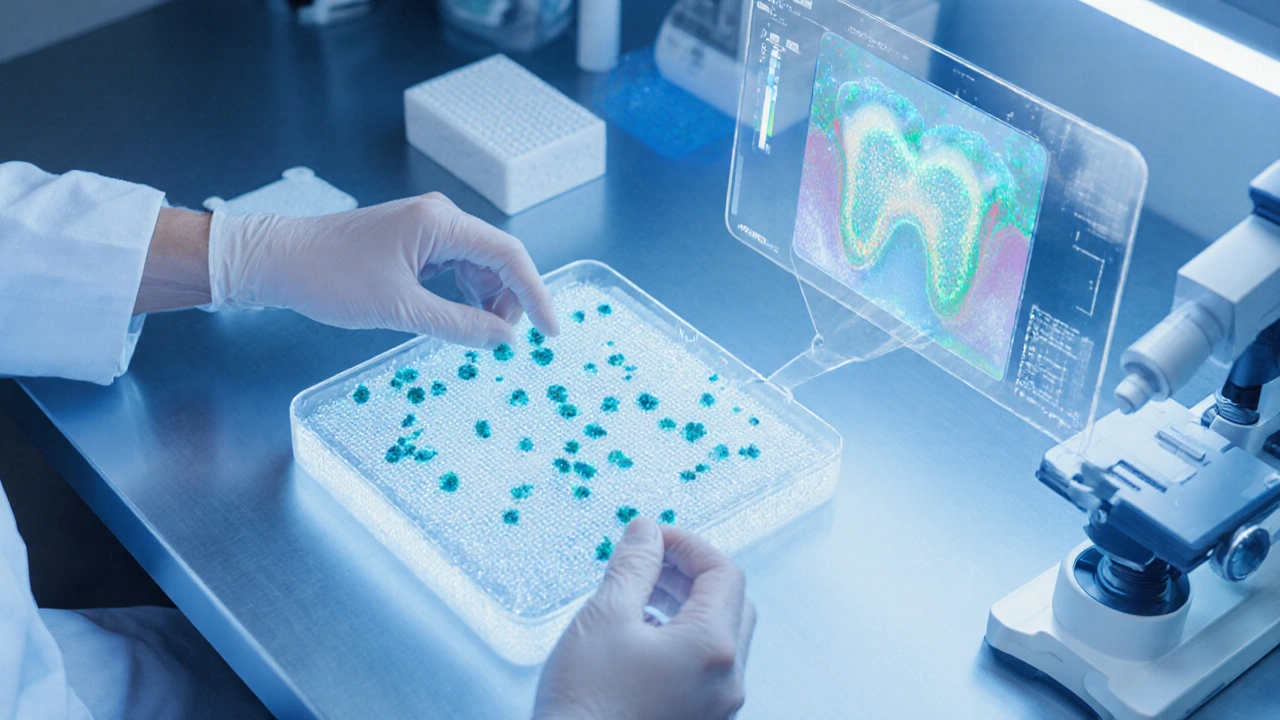

Časový šetřič buňkové terapie
Vypočítejte časovou úsporu
Zadejte počet měsíců tradičního rovnátka a zjistěte, kolik času ušetříte
Časová úspora: 0–0 měsíců
Buněčná terapie vyžaduje 4–8 měsíců
Každý, kdo se dívá do zrcadla a vidí křivé zuby, si představuje, jak by byl úsměv rovnější a sebevědomější. Tradiční rovnátka často vyžadují roky nosení a mohou být nepohodlná. Co kdyby existovala metoda, která opraví zuby rychleji a bez viditelných aparátů? buněčná terapie regenerativní přístup využívající živé buňky k obnově a přetvoření tkání, včetně zubních struktur nabízí právě takovou alternativu.
Co je buněčná terapie a jak funguje v ústech?
Jedná se o techniku, která využívá kmenové buňky primární buňky schopné diferenciace do různých typů tkání, včetně dentinových a cementových buněk. Buňky se získají buď z vlastní dřeně, nebo z pulpální tkáně zubu, který se odstraní při rutinním zákroku. V laboratoři se buňky kultivují, rozšiřují a připraví se takzvané „skrutky“ - nosiče z biomateriálů, které podporují růst a orientaci nových buněk.
Tradiční ortodontie vs. inovativní přístup
Standardní ortodontické aparáty mechanické zařízení (rovnátka, alignery) připojené na zuby a využívající sílu k jejich postupnému posunu jsou osvědčené, ale mají nevýhody: dlouhá doba léčby, hygiena, estetika a riziko dekolorizace zubu. Buněčná terapie přistupuje k problému jinak - místo tahání zubu se zaměřuje na remodelaci alveolární kosti a zubního kořene tak, aby se zuby přirozeně usadily do správné pozice.
Klíčové kroky celého procesu
- Rozhovor a diagnostika - zubní lékař provede 3D sken a stanoví, které zuby je možné korigovat pomocí buněk.
- Odběr buněk - buňky se získají z dentinové pulpové tkáně během minimálně invazivního zákroku.
- Laboratorní příprava - biomateriály biokompatibilní skvrny (např. kolagenový hydrogel) slouží jako podpůrná struktura pro růst nových buněk a kultivace kmenových buněk trvají 2-4 týdny.
- Implantace - připravené buněčné „skrutky“ se zavádějí do alveolární kosti pod kontrolou mikroskopu.
- Regenerace a sledování - během následujících měsíců dochází k přirozenému přetvoření kosti a zub se automaticky usazuje do nové, rovnější polohy.
Porovnání: tradiční rovnátka vs. buněčná terapie
| Parametr | Tradiční rovnátka | Buněčná terapie |
|---|---|---|
| Doba léčby | 12-36 měsíců | 4-8 měsíců |
| Estetika během léčby | Viditelné aparáty / alignery | Žádné viditelné prvky |
| Riziko poškození skloviny | Střední - častá demineralizace | Nízké - buňky podporují regeneraci |
| Požadavek na ústní hygienu | Vysoký - nutnost čistit kolem aparátů | Standardní - běžná hygiena |
| Možnosti korekce komplexních vad | Omezené na posun. | Možnost remodelace kosti a dokonce omlazení periodontu |
Bezpečnost a klinické důkazy
Na českém i mezinárodním poli existuje řada klinických studií průzkumů, které hodnotí účinnost a bezpečnost buněčných terapií v odontologii. Většina výzkumu potvrzuje, že riziko alergické reakce je <1% a že dlouhodobá stabilita výsledku je srovnatelná s běžnou ortodoncií. Hlavní kontraindikace zahrnují: aktivní onemocnění dásní, nekompenzovaná cukrovka a látkové poruchy imunitního systému.
Kde lze terapii absolvovat v České republice?
V současnosti nabízí Brněnská stomatologická klinika vedená týmem specialistů na regenerativní stomatologii, kde probíhají jak diagnostika, tak i aplikace buněčných terapií kompletní balíček - od odběru buněk po finální kontrolu. Cena se pohybuje mezi 80000 a 120000 Kč, což zahrnuje laboratoř, materiály i následné kontroly. Většina pojišťoven zatím nehradí, ale některé soukromé nízkonákladové plány mohou část nákladů pokrýt.

Skutečný příběh - jak to vypadá v praxi
Jana, 28 let, se po dvou letech nošení viditelných aparátů rozhodla vyzkoušet buněčnou terapii. Po odběru pulpových buněk a jejich kultivaci byla v červenci 2024 implantována první dávka do alveolární kosti pravého horního řezáku. Už po šesti týdnech zaznamenala menší posun a po čtyřech měsících měl její úsměv rovný profil bez jakýchkoliv viditelných nosičů. Jana uvádí, že největší výhodou byla rychlost a absence nepohodlí spojeného s rovnátky.
Jak začít - praktické tipy
- Vyhledejte specialistu s certifikací v regenerativní stomatologii.
- Nechte si udělat 3D sken a konzultaci, kde lékař posoudí vhodnost buňkové terapie pro váš konkrétní případ.
- Zajistěte si kvalitní laboratoř, která používá 3D tisk technologii pro výrobu přesných nosičů a implantátů na míru.
- Plánujte pravidelné kontroly během první fáze regenerace - obvykle každé 4-6 týdnů.
- Pamatujte na standardní ústní hygienu a vyhýbejte se konzumaci tvrdých potravin alespoň první měsíc po zákroku.
Po přečtení všeho výše víte, že buněčná terapie není jen futuristická sci‑fi, ale reálná metoda, která může změnit způsob, jakým řešíme křivé zuby. Pokud hledáte rychlou, estetickou a dlouhodobě stabilní alternativu, stojí za to prozkoumat tuto možnost u odborníka.
Často kladené dotazy
Jak dlouho trvá celá léčba?
Od odběru buněk po finální korekci obvykle 4‑8 měsíců, v závislosti na rozsahu korekce a individuální reakci tkání.
Bolí odběr buněk?
Odběr pulpových buněk probíhá během krátkého lokálního anestezie, takže pacient necítí výraznou bolest.
Jsou výsledky trvalé?
Ano, pokud se dodržuje doporučená ústní hygiena a pravidelné kontroly, úprava zůstává stabilní po mnoho let.
Kolik to stojí a co pojišťovna hradí?
Cena se pohybuje mezi 80000-120000Kč. Většina pojišťoven nehradí, ale některé soukromé plány mohou část nákladů pokrýt.
Kdo je vhodným kandidátem na tuto terapii?
Osoby s mírnými až středně těžkými ortodontickými vadami, zdravou dásní a bez závažných systémových onemocnění.









